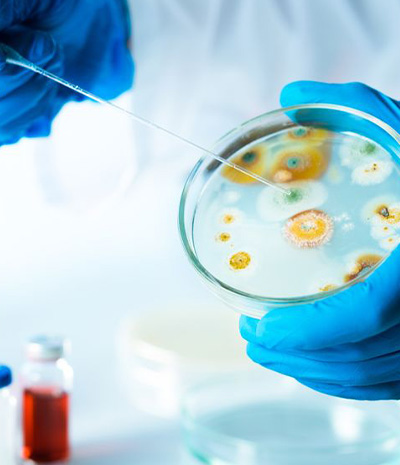
Biotechnology Division

Service Our Passion
Technology Our Trademark
YEARS EXPERIENCE
0
CUSTOMERS
0
USERS TRAINED

Engineering Division
Our Engineering Division is the leading provider of mixing & processing systems, fluid handling ...
data/images/category/2834_img_engineering.jpg
Biotechnology Division
Representing innovative and advanced Rapid Diagnostic solutions in Food, Feed, Aquaculture, Animal H...
data/images/category/2235_img_biotech.jpg
Animal Diagnostics Division
At Arachem, we believe that there should be no compromises when it comes to providing veterinary car...
data/images/category/0636_img_animal_diagnostics.jpg
Water Division
Recognizing the crucial role of water in our daily lives, we have strategically formed a new divi...
data/images/category/42230_img_arachem_water_division_photo_category.jpgOur Services
Arachem supports the philosophy of absolute reliability with services to meet your needs. We stress very much on providing the utmost services to our valued customers. We also relentlessly pursue our commitment to the customers in line with their expectation of quality, cost and performance.
Arachem maintains a very experienced and qualified team of service engineers. We also have the resources within our own & affiliated/ related companies to organize necessary support mechanism when the need arises.

CERT. NO.: QMS 01302
We provide full range of services after you have purchased one of our instruments including:
Upcoming Events
ABOUT ARACHEM
Arachem (M) Sdn Bhd success lies in its commitment in consistently delivering quality products and services. Since our inception in 1990, we have evolved into a progressive company – renowned and highly respected as the country’s leading provider of the world’s cutting-edge scientific rapid testing solution and engineering systems. We are also highly sought by the private sectors and government agencies for our up-to-date product knowledge and technical expertise.
Arachem continues to attract a diverse portfolio of clients involved in various industries, notably water and wastewater treatment, food and beverage, agriculture, aquaculture, animal health diagnostic, chemical manufacturing, palm oil as well as pharmaceutical.



.png)
.png)











